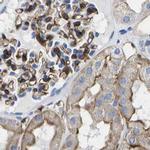
Dysferlin Antibody in Immunohistochemistry (IHC)

Search
Invitrogen
Dysferlin Polyclonal Antibody
{{$productOrderCtrl.translations['antibody.pdp.commerceCard.promotion.promotions']}}
{{$productOrderCtrl.translations['antibody.pdp.commerceCard.promotion.viewpromo']}}
{{$productOrderCtrl.translations['antibody.pdp.commerceCard.promotion.promocode']}}: {{promo.promoCode}} {{promo.promoTitle}} {{promo.promoDescription}}. {{$productOrderCtrl.translations['antibody.pdp.commerceCard.promotion.learnmore']}}
产品信息
PA5-53546
种属反应
宿主/亚型
分类
类型
抗原
偶联物
形式
浓度
规格
纯化类型
保存液
内含物
保存条件
运输条件
RRID
产品详细信息
Immunogen sequence: IVVELYDHDT YGADEFMGRC ICQPSLERMP RLAWFPLTRG SQPSGELLAS FELIQREKPA IHHIPGFEVQ ETSRILDESE DTDLPYPPPQ REANIYMVPQ NIKPALQRTA IEILAWG
Highest antigen sequence identity to the following orthologs: Mouse - 96%, Rat - 96%.
靶标信息
Dysferlin is the protein product of the 2p13 gene that is defective in patients with Limb-Girdle Muscular Dystrophy type 2B (LGMD2B) and Miyoshi Myopathy (MM). Dysferlin is normally localized to the muscle plasma membrane. In patients with LGMD2B and MM, immunoreactivity to dysferlin is severely reduced or lost, depending on the type of mutation. This antibody is used for the characterization of LGMD2B and MM.
仅用于科研。不用于诊断过程。未经明确授权不得转售。
篇参考文献 (0)
生物信息学
蛋白别名: DYSF_v1; Dysferlin; dystrophy-associated fer-1-like 1; Dystrophy-associated fer-1-like protein; fer-1-like family member 1; Fer-1-like protein 1; FLJ00175; FLJ90168; limb girdle muscular dystrophy 2B (autosomal recessive); unnamed protein product
基因别名: DYSF; FER1L1; LGMD2B; LGMDR2; MMD1
UniProt ID: (Human) O75923
Entrez Gene ID: (Human) 8291